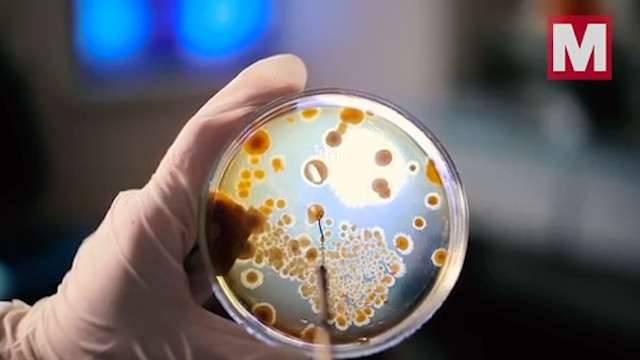
5 günlük makarna yiyen genç ölü bulundu!  - Resim: 4

5 günlük makarna yiyen genç ölü bulundu!

Belçika'nın Brüksel kentinde 20 yaşındaki AJ isimli genç, mutfak tezgahında duran 5 günlük makarnayı yediği için hayatını kaybettiği açıklandı.

Olay aslında 2008 yalında yaşandı. Ancak işin aslı 11 yıl sonra ortaya çıktı. Belçika'da 20 yaşındaki gencin 5 günlük makarna yediği için hayatını kaybettiği belirtildi.

2008 yılında Belçika'nın Brüksel kentinde 20 yaşındaki AJ isimli genç, mutfak tezgahında duran 5 günlük makarnayı yedi. AJ kısa süre sonra kendisini kötü hissetmeye başladı.

Zehirlendiğini düşünen AJ bol bol su içti. Olayın gecesinde birkaç kez kusan AJ'in cansız bedeni yakınları tarafından bulundu.
20 yaşındaki talihsiz gencin ölüm sebebi yıllar sonra bulundu. AJ'in ölümüne 'bacillus cereus' adlı bakterin neden olduğu açıklandı.